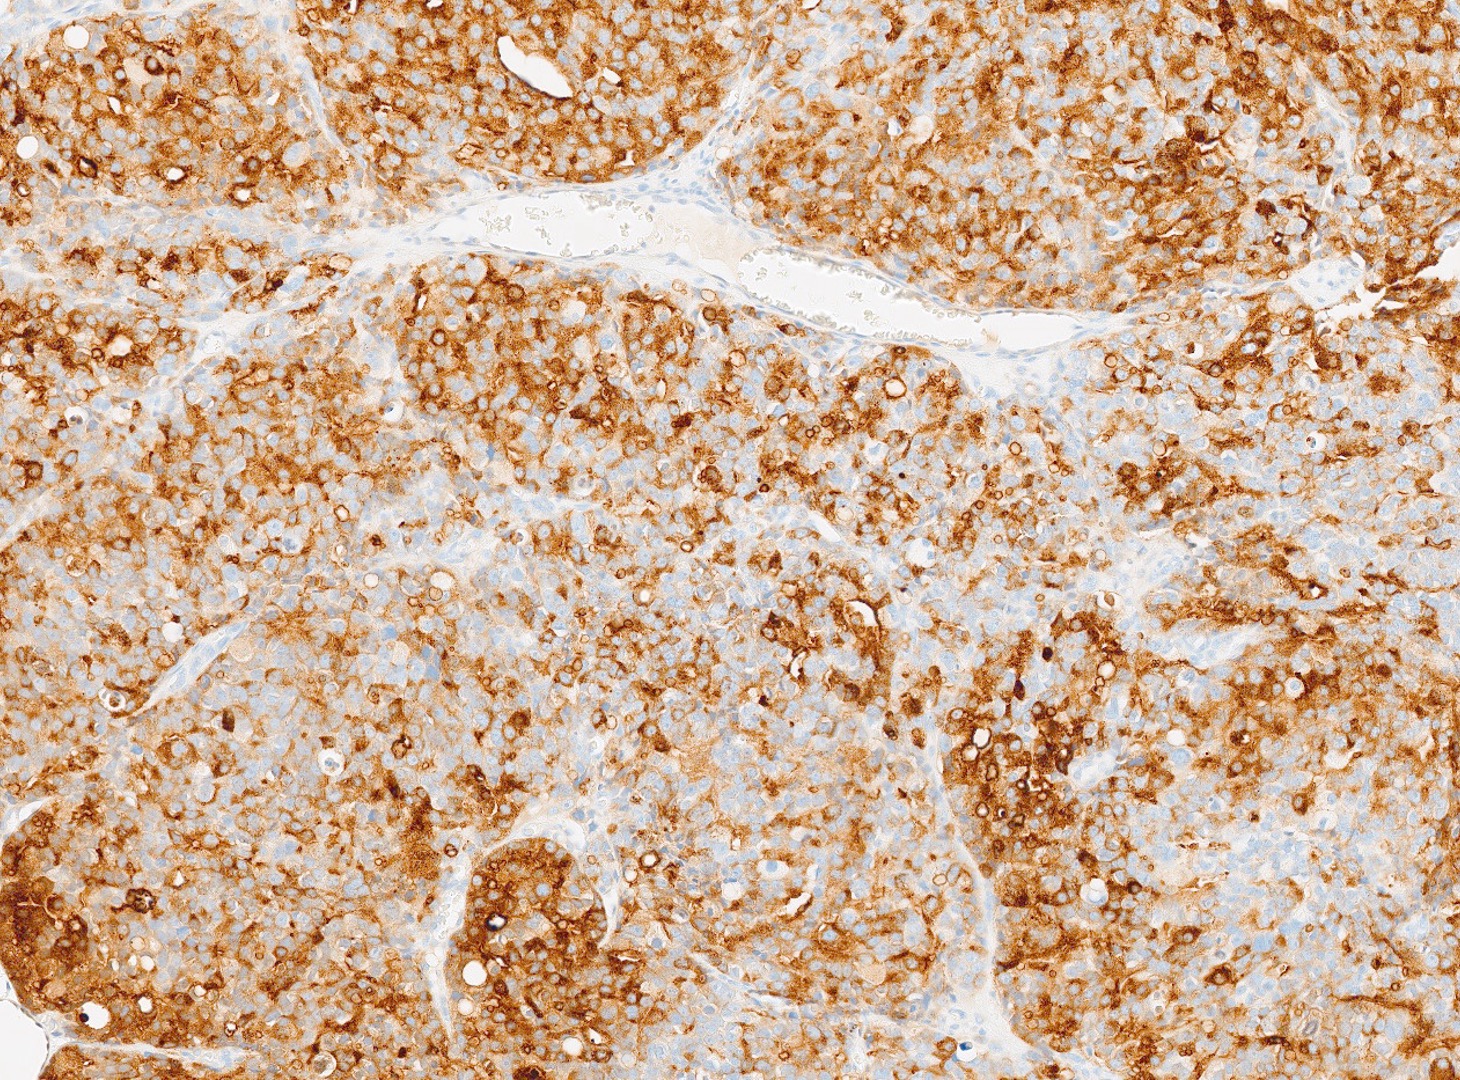

Case Study #6
March 2026 - 72 year-old Male
The patient is a 72-year-old male with a history of urinary hesitancy and nocturia, previously attributed to benign prostatic hyperplasia (BPH). He presented to his primary care physician with a 3-month history of unintentional weight loss (~12 lbs), fatigue, and right upper quadrant abdominal discomfort. No history of jaundice, hepatomegaly on exam, or alcohol use disorder. A CT abdomen/pelvis with contrast revealed multiple hypodense lesions in both hepatic lobes, the largest measuring 3.1 cm in segment VI, concerning for metastatic disease. The prostate was enlarged, but no discrete mass was identified on imaging. Bone scan showed sclerotic lesions in the pelvis and lumbar spine, consistent with osseous metastases. A liver biopsy was obtained from the largest lesion in the right hepatic lobe for diagnostic confirmation.
What is the diagnosis?

GU Pathology
GU Pathology